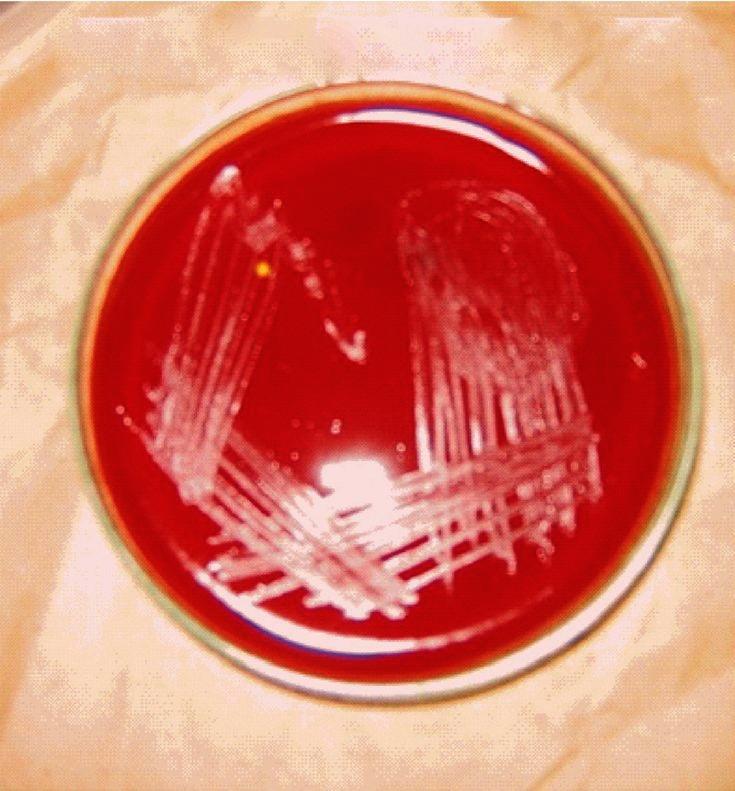
https://cdn.ncbi.nlm.nih.gov/pmc/blobs/8f69/3657863/02c5459fc305/IJMR-137-380-g002.jpg

用常规和分子方法鉴定和描述汉赛巴尔通体的策略。
Strategy for identification & characterization of Bartonella henselae with conventional & molecular methods.
机构信息
Department of Microbiology, All India Institute of Medical Sciences, New Delhi, India.
出版信息
Indian J Med Res. 2013 Feb;137(2):380-7.
BACKGROUND & OBJECTIVES: Bartonella henselae is a fastidious gram-negative bacterium usually causing self limiting infections in immunocompetent individuals but often causes potentially life threatening infection, such as bacillary angiomatosis in immunocompromised patients. Both diagnosis of infections and research into molecular mechanisms of pathogenesis have been hindered by lack of appropriate and reliable diagnostic techniques. We undertook this study to standardize methods to characterize B. henselae in clinical samples to diagnose Bartonella infection correctly.
METHODS
B. henselae ATCC 49882 strain was procured from American type culture collection, USA. This strain was revived and maintained in the laboratory, and identification and characterization of this strain was done by conventional and molecular techniques, which included culture on various media, staining by different methods including electron microscopy, biochemical analysis by conventional methods and API, polymerase chain reaction (PCR) for amplification of citrate synthase gene followed by restriction fragment length polymorphism (RFLP).
RESULTS
This organism was biochemically inert due to slow growth and generated unique identification code with API. The amplification of the citrate-synthase gene with primers yielded a 381 bp product followed by specific RFLP profile for B. henselae.
INTERPRETATION & CONCLUSIONS: Bartonella is fastidious and fragile organism and should be handled carefully. Extra effort and careful observation are required to isolate and characterize this organism.
背景与目的
巴尔通体(Bartonella)是一种苛刻的革兰氏阴性细菌,通常在免疫功能正常的个体中引起自限性感染,但在免疫功能低下的患者中常引起潜在的危及生命的感染,如杆菌性血管瘤病。由于缺乏适当和可靠的诊断技术,感染的诊断和发病机制的分子机制研究都受到了阻碍。我们进行这项研究是为了标准化用于从临床样本中鉴定巴尔通体(Bartonella)的方法,以正确诊断巴尔通体感染。
方法
从美国典型培养物保藏中心(American Type Culture Collection,USA)获得巴尔通体(Bartonella)菌株 ATCC 49882。该菌株在实验室中复苏和保存,并通过常规和分子技术进行鉴定和特征描述,包括在不同培养基上的培养、不同方法的染色,包括电子显微镜、传统 API 的生化分析、扩增柠檬酸合酶基因的聚合酶链反应(PCR),随后进行限制性片段长度多态性(RFLP)分析。
结果
该生物体由于生长缓慢而具有生化惰性,并通过 API 产生独特的识别码。使用引物扩增柠檬酸合酶基因可得到 381bp 的产物,随后是巴尔通体(Bartonella)的特异性 RFLP 图谱。
解释与结论
巴尔通体(Bartonella)是一种苛刻而脆弱的生物体,应小心处理。需要额外的努力和仔细观察才能分离和鉴定该生物体。